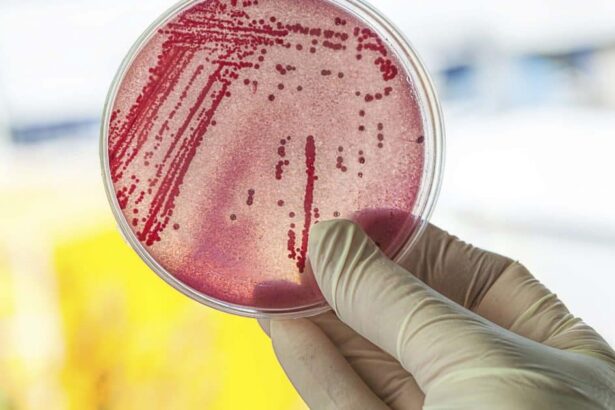

Các chuyên gia Úc phát hiện ra rằng một căn bệnh tình dục “xưa như trái đất”, vẫn được cho rằng chỉ lây qua đường tình dục, có thể dễ dàng “nhảy” qua một nụ hôn!
Nghiên cứu mới từ Đại học Monash (Úc) đã phát hiện ra một đường lây mới của căn bệnh tình dục “xưa như trái đất”: bệnh lậu. Trước đây, người ta tin rằng bệnh chỉ lây qua đường tình dục, bao gồm quan hệ tình dục kiểu truyền thống và lây qua sự tiếp xúc nước bọt – dịch sinh dục khi quan hệ đường miệng (oral sex) và khi chia sẻ đồ chơi tình dục. Tuy nhiên, công trình lần này chứng minh vi khuẩn lậu có thể lây truyền chỉ qua một nụ hôn thông thường.
Tiến sĩ Eric Chow, trưởng nhóm nghiên cứu, cho biết mọt số bằng chứng cho thấy việc bệnh lây truyền theo đường hầu họng phổ biến hơn so với suy nghĩ trước đây. Với một nụ hôn sâu kiểu Pháp, tức có sự tiếp xúc nước bọt nhiều, căn bệnh tưởng chừng chỉ lây qua đường tình dục này đã đủ để lan truyền.
Khi đó, người bệnh thường sẽ phát sinh dạng bệnh lậu ở hầu họng, bao gồm các triệu chứng như đau họng, sưng hạch bạch huyết ở cổ. Khảo sát trên hơn 3.000 người đồng tính nam và người lưỡng tính cho thấy nguy cơ họ mắc bệnh lậu ở hầu họng còn cao hơn ở vùng sinh dục.

Một nụ hôn sâu đủ khiến bạn bị lây bệnh lậu, nghiên cứu mới cảnh báo – ảnh minh họa từ internet
Kết quả nuôi cấy vi khuẩn N. gonorrhoeae gây bệnh lậu trong nước bọt được tiến hành ở phòng thí nghiệm cũng xác định khả năng lây truyền cao qua tiếp xúc nước bọt – nước bọt.
Các tác giả lưu ý rằng dù nhóm được khảo sát là người đồng tính nam, nhưng việc lây truyền bệnh lậu qua nụ hôn đúng cả với người dị tính.
Biết được đường lây mới của căn bệnh tình dục phổ biến này sẽ giúp các bác sĩ có phương án đối phó tốt hơn, cũng như lý giải được nhiều trường hợp bệnh nhân không hiểu vì sao mình mắc bệnh, vì không hề có quan hệ tình dục thực sự với bất kỳ đối tượng nguy cơ nào.
Nhóm nghiên cứu đang tiến hành thử nghiệm một số loại nước súc miệng diệt khuẩn xem chúng có giúp loại bỏ phần nào mầm bệnh lậu, giảm nguy cơ lan truyền hay không.

No comments.
You can be the first one to leave a comment.